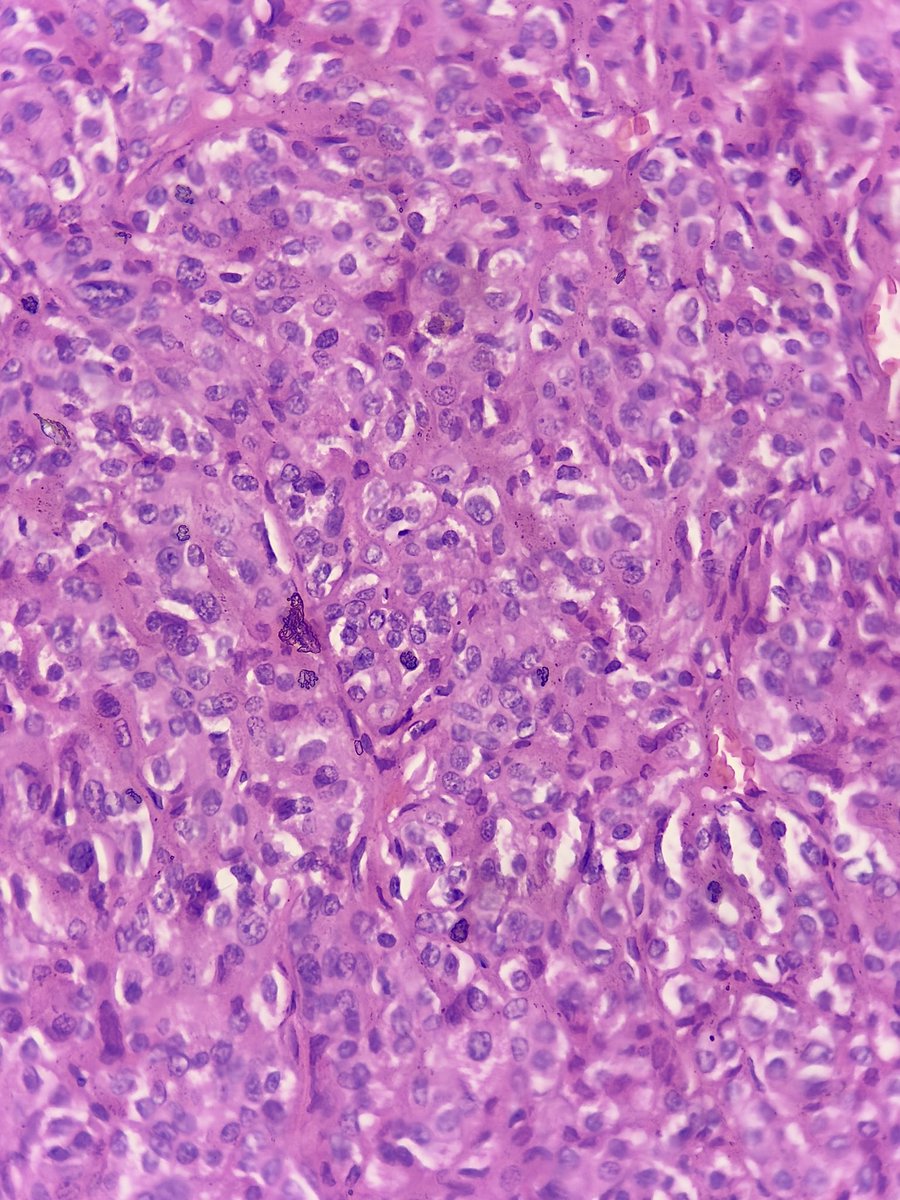
megha_lalcheta's tweet image. 34/F, #Parotid mass!!! 
#EndoPath 

Diagnosis?

#PathX #Pathology #PathResidents #Surgpath #Pathtwitter #Pathologists
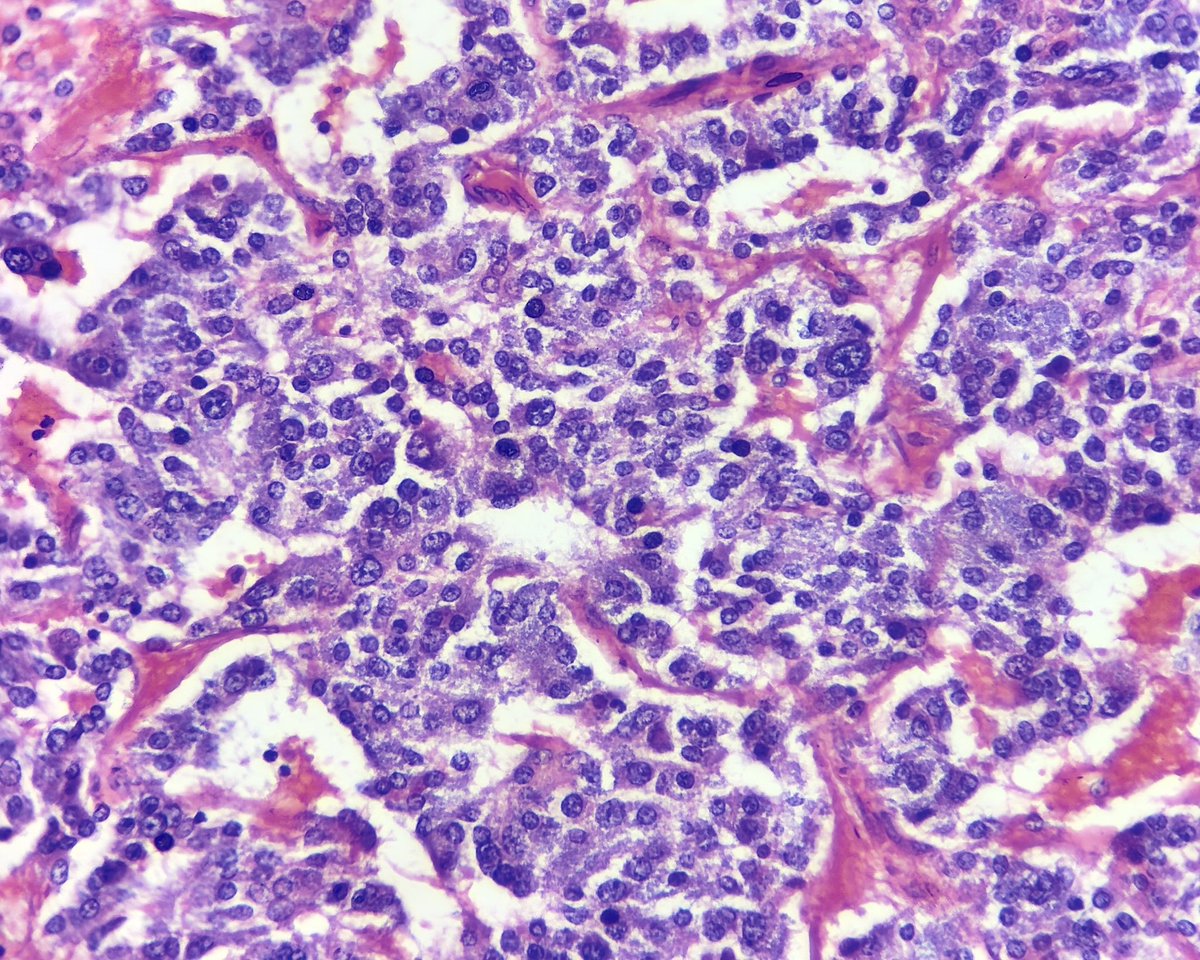
megha_lalcheta's tweet image. Adrenal mass, 60/F. 

#Endopath #Surgpath #Pathology #Pathresidents #PathX #Pathtwitter #Adrenal 
Your opinion?
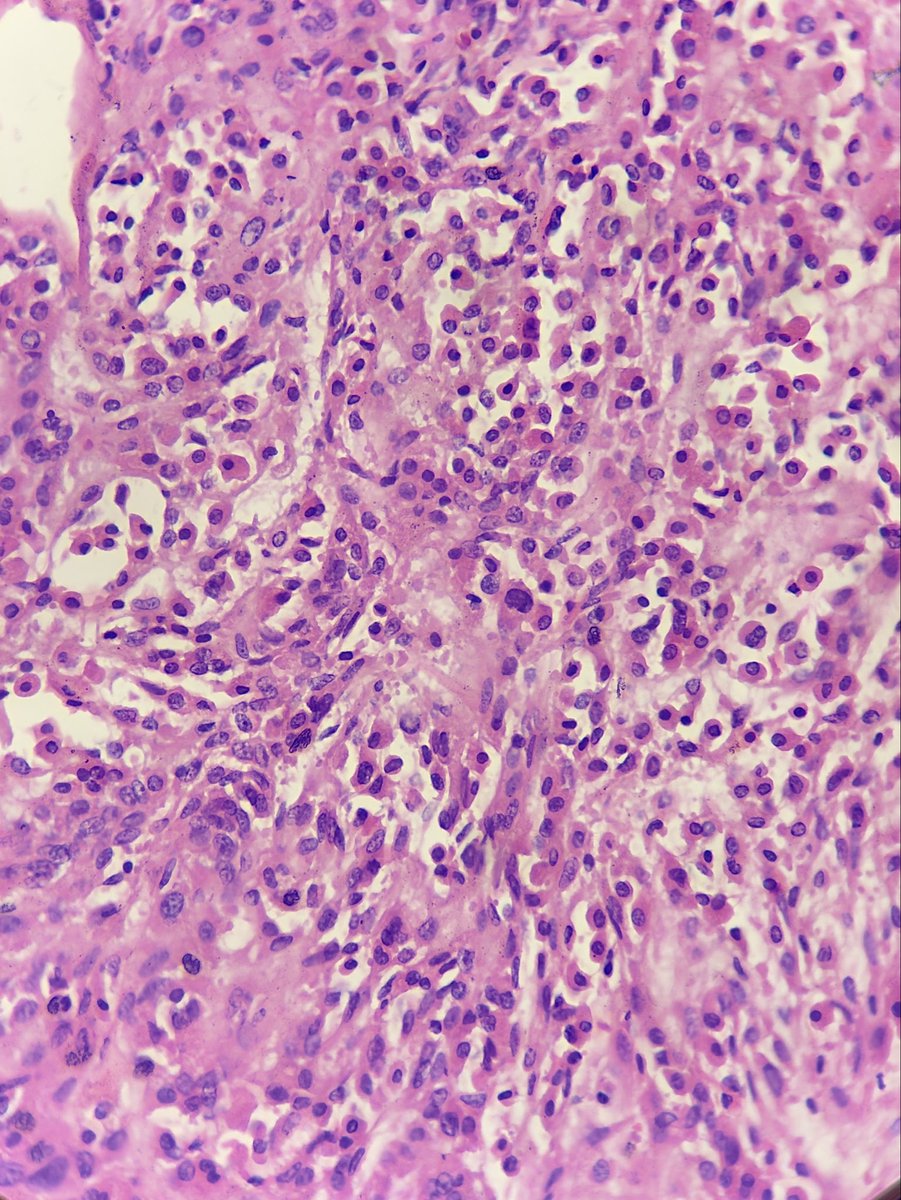
megha_lalcheta's tweet image. Few more microscopic images….. 
suggested ihc markers? 

#Parotid mass #EndoPath #PathX #Pathology

#endopath search results
FNA from a 45yo man with a history of pheochromocytoma, what is your interpretation? A) Papillary thyroid carcinoma B) Follicular Neoplasm C) Medullary thyroid carcinoma D) Metastatic pheochromocytoma #CytoPath #EndoPath #PathTwitter #Pathology

___mutation-associated pheochromocytomas follow a pseudohypoxia-related pathway A) RET B) VHL30925729 C) NF1 D) MEN1 🔬tumourclassification.iarc.who.int/Viewer/Index2?… #EndoPath #PathTwitter #Pathology

50yo ♀ thyroid, 1st impression? A) PTC, diffuse sclerosing variant B) Hashimoto thyroiditis, fibrosing variant C) Riedel thyroiditis 🔬virtualpathology.leeds.ac.uk/slides/library… #Thyroid #EndoPath #ENTPath #PathTwitter #Pathology #Pathologists

More from arppress.org/books/book/68: Medullary thyroid carcinoma is a malignant thyroid tumor composed of cells showing evidence of C-cell differentiation. 25-30% are associated with hereditary germline RET mutations. #EndoPath #HNPath #ENTPath



Thyroid mass, 1st impression? A) Synovial sarcoma B) Intrathyroid thymoma C) Spindle epithelial tumor with thymus-like elements 🔬tumourclassification.iarc.who.int/Viewer/Index2?… #BSTPath #EndoPath #PathTwitter #pathology

Pheochromocytomas with ___ mutations are more frequently metastatic A) SDHB B) VHL C) RET (MEN2) D) NF1 #EndoPath #PathTwitter #Pathology #BSTPath #PediPath

getting #endopath vibes from #GUpath kidney? sometimes clear cell RCC (as shown) can have luminal secretion vaguely reminiscent of thyroid follicles (and mimic thyroid-like follicular carcinoma of kidney)



interesting #endopath/#GUpath adrenal🔬: pheochromocytoma with brown fat in surrounding adipose tissue @AMubeen_Path @DrCristinaMagi had a nice @TheUSCAP abstract on this topic a few years back



#endopath: 😍🔬aldosterone-secreting adrenal cortical adenoma (Conn syndrome), s/p prior Rx w/spironolactone add'l learning points: - number of spironolactone bodies typically peaks 4-6 week after spironolactone Rx - usually DO NOT see bodies with novel Rx agent eplerenone




Q for the #endopath folks for this adrenal cortical adenoma (clinical: primary aldo) intratumor/adrenal fat I've seen, perhaps not all that uncommon... but intratumoral/adrenal brown fat? usually I see brown around the peripheral (within background excised fat) when it occurs




Join @GU_Path_Society Tomorrow for the February 2024 Virtual Education Series Event ADRENAL NEOPLASIA Register here: us02web.zoom.us/webinar/regist… #gupath #endopath @Shounak_Gupta @TretiakovaMaria @PathDocBoston @rajalbshah @priyaraomd @drmehrarohit @AkgulMD @ShivaniKandu
Excited to announce our 2nd lecture of our Virtual Education Series in February on Adrenal neoplasia. Register in advance for this webinar: us02web.zoom.us/webinar/regist…

Adrenal Neoplasia Pathology @GU_Path_Society Virtual Education Session HAPPENING NOW! Dr. Ozgur Mete @UofT_LMP presents: 2022 WHO Updates in Adrenal Pathology @Shounak_Gupta @TretiakovaMaria #gupath #endopath



Excited to announce our 2nd lecture of our Virtual Education Series in February on Adrenal neoplasia. Register in advance for this webinar: us02web.zoom.us/webinar/regist…

We're rounding out January with a special Case of the Month in honor of thyroid awareness month. See the images and poll below and test your knowledge! Answer and discussion out tomorrow. #EndoPath #HNPath #ThyroidAwareness


adult M with single adrenal mass, adrenalectomy: 🤔having trouble classifying this oncocytic adrenal neoplasm? 🔑that's b/c it's #endopath⏩#GUpath‼️ 🔬Dx: metastatic prostatic adenocarcinoma (patient had h/o GG5 PCA)




Kindly share your thoughts on this: Late 30s, About 4 years of recurring headache and worsening vision bilaterally. 👨🏾⚕️🔪-Well encapsulated huge suprasellar mass ?Pituitary macroadenoma No access to IHCs. #CNSPath #Neuropath #Endopath #Pathology



More from arppress.org/books/book/68: Papillary thyroid carcinoma has many variants including tall cell type, characterized by cell height at least 2x the width (>30%), often eosinophilic cytoplasm, and more aggressive clinical behavior. #EndoPath #ENTpath #HNPath


#endopath holiday🎁! adrenalectomy for small mass, limited history had to hunt🔬but found spironolactone bodies😍! digging through chart, found out patient had hyperaldosteronism & was treated with spironolactone I tend to see🔬these in oncocytic component (vs clear cells)




What’s your opinion? Part 2… #Parotid_mass #Surgpath #Endopath
34/F, #Parotid mass!!! #EndoPath Diagnosis? #PathX #Pathology #PathResidents #Surgpath #Pathtwitter #Pathologists

It only took 6 seconds. 25G. No anesthesia, almost imperceptible to the patient, on-site assessment 🔬, and certainty of a sufficient sample, in both quality and quantity. What more could you ask for? #FNAFriday #CytoPath #EndoPath




Metastatic medullary thyroid carcinoma to spine and pelvis. #ENTPath #EndoPath #ThyroidPath #HeadandNeckPath Upon detailed questioning, the patient reported a history of thyroidectomy 10 years ago; however, no medical records are available for verification.
adult M with single adrenal mass, adrenalectomy: 🤔having trouble classifying this oncocytic adrenal neoplasm? 🔑that's b/c it's #endopath⏩#GUpath‼️ 🔬Dx: metastatic prostatic adenocarcinoma (patient had h/o GG5 PCA)




The prognostic impact of blood vessel invasion in infiltrative papillary thyroid carcinoma: a retrospective case–control study - Ghossein - Histopathology - Wiley Online Library #endopath #openaccess onlinelibrary.wiley.com/doi/10.1111/hi…
Anaplastic thyroid carcinoma with liposarcomatous foci: a novel heterologous differentiation - Piana - Histopathology - Wiley Online Library #endopath onlinelibrary.wiley.com/doi/10.1111/hi…
interesting #endopath/#GUpath adrenal🔬: pheochromocytoma with brown fat in surrounding adipose tissue @AMubeen_Path @DrCristinaMagi had a nice @TheUSCAP abstract on this topic a few years back



More from arppress.org/books/book/68: Papillary thyroid carcinoma has many variants including tall cell type, characterized by cell height at least 2x the width (>30%), often eosinophilic cytoplasm, and more aggressive clinical behavior. #EndoPath #ENTpath #HNPath


TRPS1 expression in neuroendocrine neoplasms of breast and other organs - Ye - Histopathology - Wiley Online Library #breastpath #endopath https://online library.wiley.com/doi/10.1111/hi…
Adrenal mass, 60/F. #Endopath #Surgpath #Pathology #Pathresidents #PathX #Pathtwitter #Adrenal Your opinion?
Tiroiditis de Hashimoto👀 🔸️Enfermedad autoinmune con ⬆️Ac antiperoxidasa y antitiroglobulina en 🩸. 🔸️+común en ♀️edad media. 🔸️Clínica de hipotiroidismo. 🔸️Macro: ⬆️tamaño tiroides (2-3×), irregular. 🔸️🔬:infiltrado linfoplasmocitario+ folículos atróficos. #EndoPath




____ Follicular Variant Papillary Thyroid Carcinoma A) Non-invasive encapsulated B) Invasive encapsulated C) Invasive D) None of the above 🔬dpa-dapa.com/public/display… #EndoPath #ENTPath #PathTwitter #PathResidents




Q for the #endopath folks for this adrenal cortical adenoma (clinical: primary aldo) intratumor/adrenal fat I've seen, perhaps not all that uncommon... but intratumoral/adrenal brown fat? usually I see brown around the peripheral (within background excised fat) when it occurs




Columnar Cell #Thyroid Carcinoma, a subtype of #PapillaryThyroidCarcinoma or a biologically & genetically diverse, unique entity? Check it out in @HeadNeckPathol rdcu.be/dJuVZ #EndoPath #ENTPath @UChicagoPath @MGHPathology

Solid cell nests in thyroid ⭐Small (< 1 mm) interfollicular clusters of epithelial cells resembling squamous/ transitional epithelium. ⭐ Remnants of ultimobranchial body #pathtwitter #endopath #pathresidents


A 27 yo man with leg weakness? How does he present with this image, my #EndoPath friends? #EndoSurg friends, don't forget! #EmergencyMedicine #MedEd nejm.org/doi/full/10.10… @NEJM @NEJMCPC @MGHPathology

Sabías que... los patólogos utilizan el Sistema Bethesda para el diagnóstico citológico por punción de lesiones de tiroides🦋 Nueva versión 2023. 🔹️I insuficiente 🔹️II benigno 🔹️III atípico 🔹️IV neoplasia folicular 🔹️V sospechoso 🔹️VI maligno #CytoPath #EndoPath #PAAF




The Head & Neck Pathology Service @MGHPathology welcomes new faculty member, @BAlzumaili to the team! Looking forward to mentoring his great career ahead! #ENTPath #EndoPath #BreastPath @MassGeneralMDs @MassGeneralNews #Thyroid #LesionalTie

The coexistence of benign intranodal thyroid inclusions and metastatic papillary thyroid carcinoma is an underrecognized but not uncommon phenomenon. #EndoPath #ENTpath #HNpath #PathTwitter Check out our new study from @Histo_Journal onlinelibrary.wiley.com/doi/10.1111/hi…

Check out our latest “What’s New in Pathology” newsletter. June 2024 Issue: “What’s New in Adrenal Gland Pathology: WHO 5th Edition for Adrenal Cortex”: buff.ly/4ceIhgE Subscribe to this e-newsletter: buff.ly/3HzUYFK #Pathology #PathologyOutlines #EndoPath #WHO


FNA from a 45yo man with a history of pheochromocytoma, what is your interpretation? A) Papillary thyroid carcinoma B) Follicular Neoplasm C) Medullary thyroid carcinoma D) Metastatic pheochromocytoma #CytoPath #EndoPath #PathTwitter #Pathology

Couple this delightful pic from Professor Baloch (@aakasharmand) from @PennPathLabMed with matching @MGHPathology pillows fashioned before we had CYP11B2 ❤️🔬🫢 #aldosteronoma #EndoPath

When you crop out the wrinkles in your jacket but not your face! #ENTPath #EndoPath #CCHNEP23 @MGHPathology @harvardmed

getting #endopath vibes from #GUpath kidney? sometimes clear cell RCC (as shown) can have luminal secretion vaguely reminiscent of thyroid follicles (and mimic thyroid-like follicular carcinoma of kidney)



🔬Diffuse thyroid lipomatosis 🔬Associated with Amyloid goiter 🔬may be related to systemic amyloidosis, CKD or chronic infections #ENTpath #HNpath #ENDOpath




Needle bx of a large thyroid mass in a 76y/o woman after an inadequate FNA. You can appreciate both tumor and osteoblast-like giant cells at the same spot of this anaplastic thyroid carcinoma. Atypical mitosis is also noted. #thyroid #EndoPath #ENTpath #HeadandNeckPath

Something went wrong.
Something went wrong.
United States Trends
- 1. Vandy N/A
- 2. Mueller N/A
- 3. Acuff N/A
- 4. High Point N/A
- 5. chappell roan N/A
- 6. Rob Martin N/A
- 7. Arkansas N/A
- 8. Tyler Tanner N/A
- 9. Sweet 16 N/A
- 10. #Toonami N/A
- 11. byers N/A
- 12. Luke Kennard N/A
- 13. #TokyoRevengers N/A
- 14. Gonzaga N/A
- 15. Goga N/A
- 16. #AEWCollision N/A
- 17. Gordon Hayward N/A
- 18. GO BIG RED N/A
- 19. Kucherov N/A
- 20. #BlueLock N/A